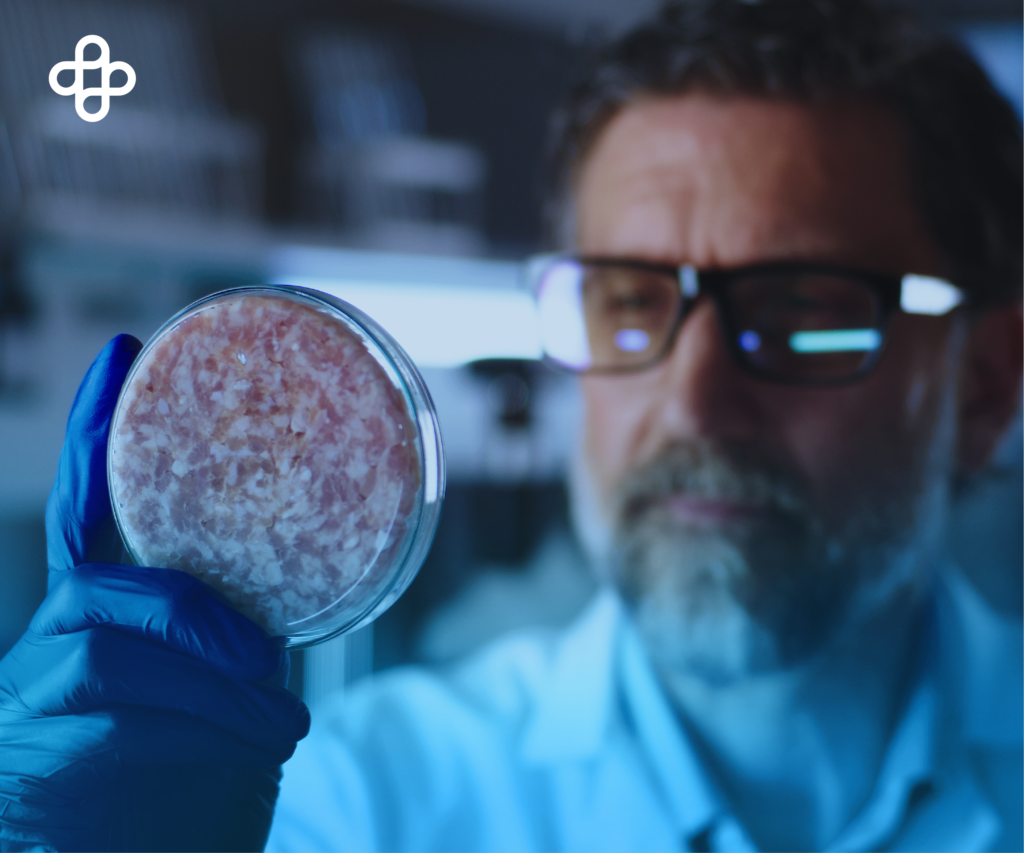
¿Qué es la medicina regenerativa?
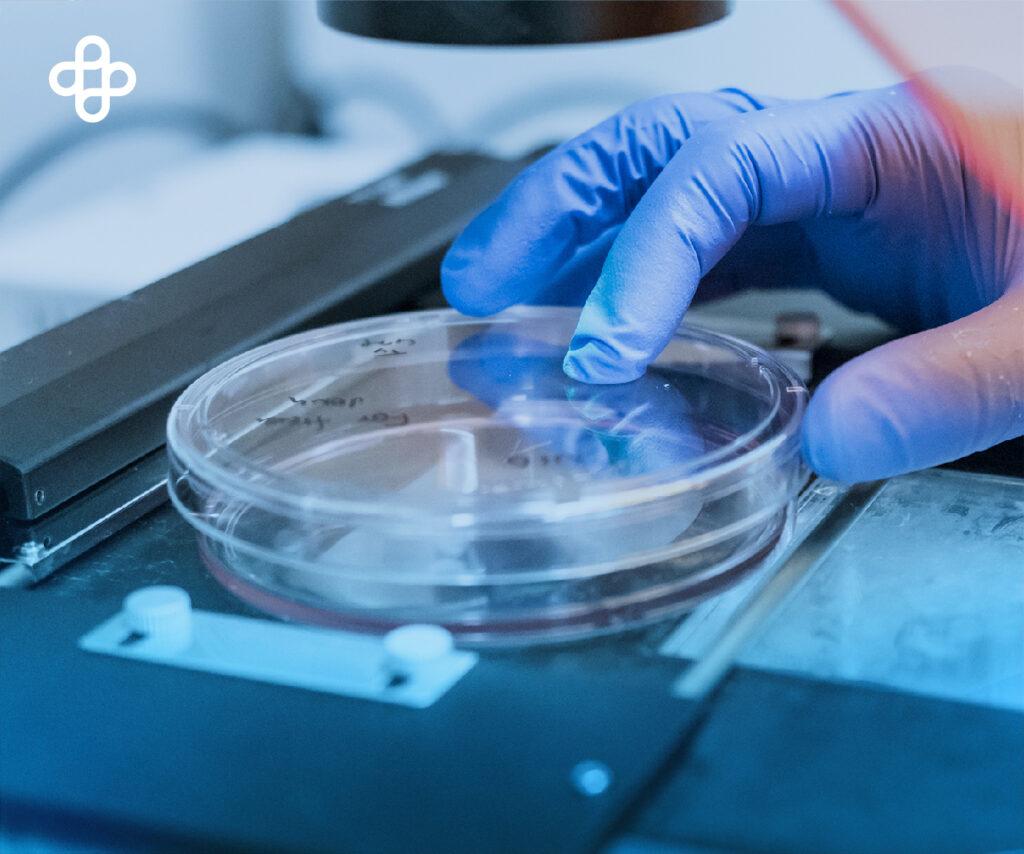
Células madre pastillas

Eternal en la Prensa: Players of Life destaca nuestro modelo de medicina regenerativa
Players of Life reconoce al Centro Médico Eternal y al Dr. Juan Garza por sus 35 años de experiencia y 15,000 pacientes tratados con medicina regenerativa en México.
Centro Médico Eternal
Equipo de Comunicación

![[ALERTA] El Exceso de Alimentos UltraProcesados Provoca 300,000 mil muertes al año en México](/_next/image?url=https%3A%2F%2Feternal.mx%2Fwp-content%2Fuploads%2F2023%2F02%2FALERTA-El-Exceso-de-Alimentos-UltraProcesados-Provoca-300000-mil-muertes-al-ano-en-Mexico_02-1024x853.jpg&w=3840&q=75)

![[ALERTA] Dieta Mexicana Aumenta el Riesgo frente al COVID19](/_next/image?url=https%3A%2F%2Feternal.mx%2Fwp-content%2Fuploads%2F2023%2F02%2FALERTA-Dieta-Mexicana-Aumenta-el-Riesgo-frente-al-COVID19_02-1024x853.jpg&w=3840&q=75)

















































































